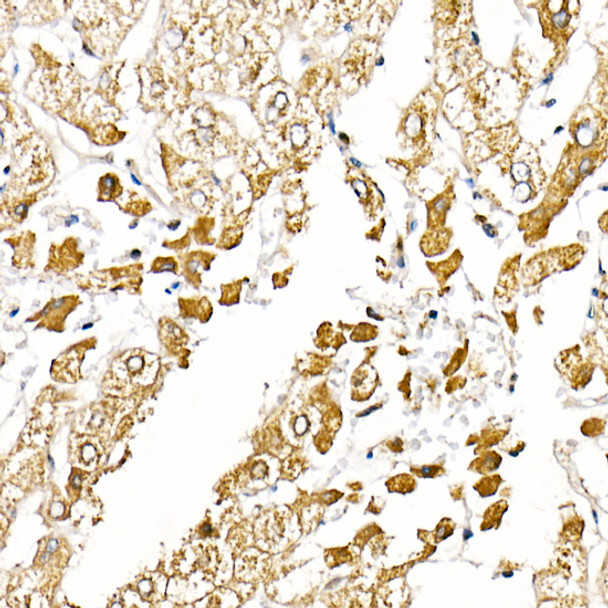
Caspase-1 Polyclonal Antibody (CAB21296)

Description
Caspase-1 Polyclonal Antibody (CAB21296)
The Caspase-1 Polyclonal Antibody is a valuable tool for researchers studying the role of Caspase-1 in the immune system and inflammatory processes. Caspase-1 is a key enzyme involved in the activation of pro-inflammatory cytokines, making it a crucial target for understanding and developing treatments for inflammatory diseases.This antibody, generated in rabbits, is highly specific to human Caspase-1 and has been validated for use in Western blot applications. By binding to Caspase-1, researchers can accurately detect and analyze the protein in various cell types, providing valuable insights into its function and regulation.
Studies have shown that dysregulation of Caspase-1 activity is associated with various inflammatory conditions, including autoimmune disorders and infectious diseases. By using the Caspase-1 Polyclonal Antibody, researchers can further investigate the mechanisms underlying these diseases and potentially identify new therapeutic targets for intervention.Overall, the Caspase-1 Polyclonal Antibody is an essential tool for researchers looking to delve deeper into the role of Caspase-1 in inflammation and immune response, paving the way for novel discoveries in the field of immunology and disease research.
| Product Name: | Caspase-1 Polyclonal Antibody |
| Product Code: | CAB21296 |
| Reactivity: | Human, Mouse |
| Applications: | Immunohistochemistry, Immunofluorescence |
| Host Species: | Rabbit |
| Purification Method: | Affinity purification |
| Isotype: | IgG |
| Reactivity: | Human, Mouse |
| Tested Applications: | IHC-P, IF/ICC, ELISA |
| Key Applications: | Immunohistochemistry, Immunofluorescence |
| Recommended Dilution: | IHC-P 1:50-1:200, IF/ICC 1:50-1:200 |
| Storage Buffer: | Store at -20°C. Avoid freeze / thaw cycles.Buffer: PBS with 0.05% proclin300, 50% glycerol, pH7.3. |
| Cellular Location: | Cytoplasm |
| Customer Validation: | WB(Mus musculus, Rattus norvegicus)IHC(Homo sapiens) |
This gene encodes a protein which is a member of the cysteine-aspartic acid protease (caspase) family. Sequential activation of caspases plays a central role in the execution-phase of cell apoptosis. Caspases exist as inactive proenzymes which undergo proteolytic processing at conserved aspartic residues to produce 2 subunits, large and small, that dimerize to form the active enzyme. This gene was identified by its ability to proteolytically cleave and activate the inactive precursor of interleukin-1, a cytokine involved in the processes such as inflammation, septic shock, and wound healing. This gene has been shown to induce cell apoptosis and may function in various developmental stages. Studies of a similar gene in mouse suggest a role in the pathogenesis of Huntington disease. Alternative splicing results in transcript variants encoding distinct isoforms.
| Immunogen: | A synthetic peptide corresponding to a sequence within amino acids 198-297 of human Caspase-1 (NP_150634.1). |
| Sequence: | YSVDV KKNLT ASDMT TELEA FAHRP EHKTS DSTFL VFMSH GIREG ICGKK HSEQV PDILQ LNAIF NMLNT KNCPS LKDKP KVIII QACRG DSPGV VWFKD |
| Synonyms: | ICE, P45, IL1BC |
| Calculated MW: | 45kDa |
| Observed MW: | Refer to figures |